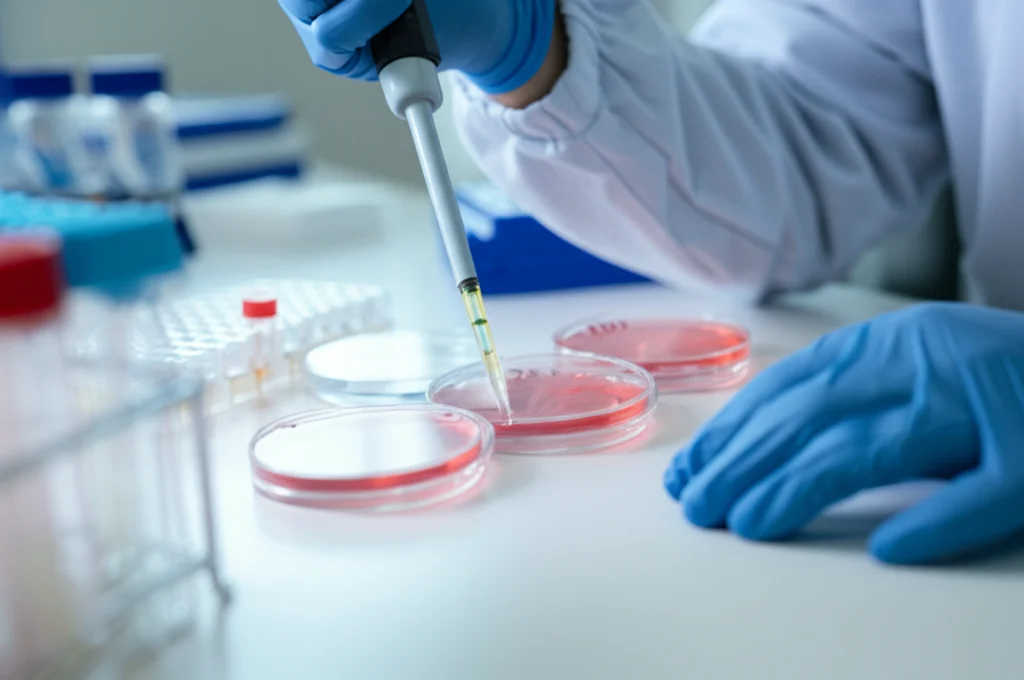
Ricercatore in laboratorio che utilizza una pipetta per trasferire campioni in piastre di coltura cellulare per analisi di cancro colon-rettale. Prime lens 35mm, depth of field, luce da laboratorio controllata.

RNA Circolari nel Cancro al Colon: Ho Svelato un Mondo Nascosto di Molecole Enigmatiche!
Ciao a tutti! Oggi voglio portarvi con me in un viaggio affascinante nel cuore della biologia molecolare, un posto dove le regole a volte sembrano fatte per essere infrante. Parleremo di cancro colon-rettale (CRC), una patologia purtroppo diffusa, ma lo faremo da una prospettiva insolita, quella degli RNA circolari (circRNA).
Magari vi state chiedendo: “RNA… circolari? Ma non erano lineari?”. Esatto! Per anni abbiamo studiato l’RNA come una molecola lineare, un messaggero che porta le istruzioni dal DNA alle fabbriche di proteine della cellula. Ma da qualche tempo abbiamo scoperto questi circRNA: anelli chiusi di RNA, stabili, enigmatici e, come stiamo capendo, incredibilmente importanti.
Un Tuffo nel Trascrittoma del Cancro
La mia curiosità mi ha spinto a indagare un fenomeno ancora più particolare: lo splicing alternativo inverso (in inglese, *alternative back-splicing*, o ABS). Immaginate un gene come un nastro con diverse sezioni (esoni). Normalmente, per creare un RNA messaggero lineare, alcune sezioni vengono tagliate via e le rimanenti unite in fila. Nel back-splicing, invece, un punto a valle si lega a uno a monte, formando un cerchio! E la cosa si complica: da uno stesso gene, tramite ABS, possono nascere *diversi* tipi di circRNA, condividendo un punto di “chiusura” all’inizio (A5BS) o alla fine (A3BS).
Fino ad oggi, però, non sapevamo quanto fosse diffuso questo fenomeno nel cancro colon-rettale, né che ruolo giocasse. Così, mi sono messo all’opera. Ho analizzato i dati di sequenziamento del trascrittoma (l’insieme di tutto l’RNA) di ben 176 campioni, tra tessuti tumorali di CRC e tessuti sani adiacenti. Volevo mappare il paesaggio degli eventi ABS in questo tipo di cancro.
Risultati Sorprendenti: l’ABS è Ovunque!
Ebbene, tenetevi forte: abbiamo identificato quasi 20.000 circRNA con alta confidenza! La cosa pazzesca è che ben il 68.8% di questi derivava da eventi di splicing alternativo inverso (ABS). Questo ci dice una cosa fondamentale: l’ABS non è un evento raro o bizzarro, ma un meccanismo prevalente nel trascrittoma del cancro colon-rettale. È come scoprire che una buona parte delle strade di una città non sono rettilinee, ma formano rotatorie multiple e complesse partendo dagli stessi incroci!
Abbiamo notato che gli eventi A5BS (quelli che condividono il sito di splicing a monte) sono leggermente più comuni degli A3BS. E non solo: un sacco di circRNA (quasi il 32%) partecipavano *sia* ad eventi A5BS che A3BS. Un bel groviglio molecolare!

ABS e Cancro: Un Legame Stretto
Ma la vera domanda era: questi circRNA da ABS c’entrano qualcosa con il cancro? Per capirlo, abbiamo confrontato i tessuti tumorali con quelli sani. Bingo! Abbiamo trovato 552 circRNA da ABS la cui “popolarità” (misurata con un indice chiamato PCU, *Percent Circularized-site Usage*) era significativamente diversa tra tumore e tessuto sano. In pratica, in presenza di cancro, la cellula “sceglie” di produrre alcuni circRNA da ABS più o meno frequentemente rispetto alla norma.
E da quali geni provenivano questi circRNA “sballati”? Analizzandoli, abbiamo visto che i loro geni “genitori” erano strettamente legati a processi biologici fondamentali che vanno in tilt nel cancro, i cosiddetti “hallmarks of cancer”: proliferazione cellulare incontrollata, resistenza alla morte cellulare, angiogenesi, metastasi… Insomma, questi circRNA sembrano essere proprio nel bel mezzo dell’azione!
Indicatori del Destino? Il Ruolo Prognostico
Un’altra scoperta emozionante è arrivata quando abbiamo incrociato i dati dei circRNA con le informazioni cliniche dei pazienti, in particolare la loro sopravvivenza (*overall survival*). Utilizzando analisi statistiche (regressione di Cox univariata e multivariata), abbiamo identificato 13 circRNA da ABS differenzialmente espressi che potevano agire come indicatori prognostici indipendenti. Questo significa che il livello di questi specifici circRNA potrebbe, in futuro, aiutarci a capire meglio l’aggressività del tumore e il probabile decorso della malattia per un paziente. Tutti questi 13 sembravano associati a una prognosi sfavorevole, suggerendo un loro ruolo nel promuovere la progressione tumorale.
La Storia di Due Gemelli Diversi: circXPO1-1 e circXPO1-2
Qui le cose si fanno ancora più intriganti. Ci siamo concentrati su un gene specifico, chiamato XPO1, noto per essere coinvolto nel trasporto di molecole fuori dal nucleo cellulare e spesso implicato nei tumori. Da questo gene, abbiamo identificato due specifici circRNA nati da un evento ABS (condividevano lo stesso sito di chiusura 3′, un A3BS): li abbiamo chiamati circXPO1-1 e circXPO1-2.
Erano simili, ma non identici (circXPO1-2 conteneva un esone in più). La prima sorpresa: studiando dove si trovavano all’interno delle cellule tumorali, abbiamo visto che circXPO1-1 stava prevalentemente nel nucleo, mentre circXPO1-2 preferiva il citoplasma. Già questo suggeriva funzioni diverse.
Poi abbiamo guardato i loro livelli: nei tessuti tumorali, circXPO1-2 era significativamente meno espresso rispetto ai tessuti sani, mentre circXPO1-1 non mostrava grandi cambiamenti. Questo calo di circXPO1-2 era ancora più marcato nei tumori in stadio avanzato. Sembrava proprio che la sua perdita fosse legata alla progressione del cancro.
Funzioni Opposte dallo Stesso Gene
A questo punto, volevamo vedere cosa succedeva *manipolando* questi due circRNA nelle cellule di cancro colon-rettale in laboratorio (linee cellulari SW620 e LoVo) e in modelli animali (topi). Abbiamo quindi “forzato” le cellule a produrre più circXPO1-1 o più circXPO1-2.
I risultati sono stati netti e sorprendenti:
- L’aumento di circXPO1-2 ha inibito significativamente la proliferazione delle cellule tumorali, la loro capacità di formare colonie, la loro migrazione e la loro invasività. Anche nei topi, i tumori crescevano molto più lentamente se le cellule esprimevano alti livelli di circXPO1-2.
- L’aumento di circXPO1-1, invece, non ha avuto alcun effetto significativo su nessuno di questi processi.
Incredibile! Due molecole di RNA circolare, generate dallo stesso gene tramite un meccanismo di splicing alternativo inverso, hanno funzioni biologiche diametralmente opposte nel contesto del cancro colon-rettale. circXPO1-2 agisce come un soppressore tumorale, mentre circXPO1-1 sembra essere neutrale. Analizzando le conseguenze molecolari dell’aumento di circXPO1-2, abbiamo visto che influenzava geni legati al ciclo cellulare, all’apoptosi (morte cellulare programmata) e a vie di segnalazione chiave come MAPK e Hippo.
Cosa Significa Tutto Questo?
Questa ricerca apre scenari davvero interessanti. Primo, abbiamo dimostrato che lo splicing alternativo inverso è un fenomeno diffusissimo nel cancro colon-rettale e genera una complessità nel trascrittoma che avevamo sottovalutato. Secondo, molti di questi circRNA da ABS sono alterati nel cancro e legati a processi tumorali chiave. Terzo, alcuni di essi potrebbero diventare nuovi biomarcatori per la diagnosi o la prognosi.
Ma la scoperta più affascinante è forse quella su circXPO1-1 e circXPO1-2: ci mostra che non basta guardare al gene di origine, ma bisogna studiare specificamente ogni isoforma circolare prodotta, perché possono avere ruoli diversissimi, persino opposti! Questo apre la porta a strategie terapeutiche innovative: e se potessimo “spingere” le cellule tumorali a produrre più circRNA “buoni” come circXPO1-2, invece delle loro controparti lineari o circolari “cattive” o “neutre”?
Il mondo degli RNA circolari è ancora in gran parte inesplorato, ma studi come questo ci fanno capire che lì dentro si nasconde un vero tesoro di informazioni e potenziali bersagli per combattere malattie complesse come il cancro. La ricerca continua!
Fonte: Springer
